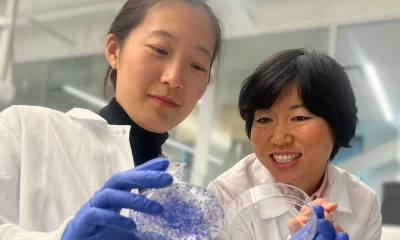

To mark International Women’s Day, Women’s HealthX released a new eBook exploring one of the biggest challenges in healthcare today:...


















A new software promises to detect breast cancer in women with dense breasts


This week we meet Talia Soen, founder and CEO of Happy Things


The method has been shown to be able to detect particles of genetic material that are left behind in the liquid media young embryos are grown...


Cryo-Logix aims to utilise clinic EMR data to ensure streamlined communication between systems


Femtech World Jobs is your go-to source for femtech recruitment opportunities We’ve rounded up our picks of posts from the past week. Head over to femtechworldjobs.com...


Diversity, equity, and inclusion (DEI) are essential elements of a thriving workplace, but how do we ensure these policies are not built on empty promises? This...


Health in Her HUE promotes a personalised and equitable approach to healthcare


Uterine fibroids remain a vastly underserved global health issue, affecting up to 80 per cent of women by the age of 50


A digital stethoscope has been shown to identify twice as many cases of peripartum cardiomyopathy as compared to regular care


The move is hoped to be an opportunity for testing important biomarkers for the more than 80 million people who menstruate in the US


With research showing 85 per cent of women who give birth vaginally experiencing some degree of tearing, we explore how perineal massage could help expectant mothers...


The new breast pump promises to simulate the baby’s tongue to optimise milk output at a faster pace


The innovations transforming reproductive medicine and giving hope to millions of prospective parents across the globe are being recognised in the Femtech World Awards. The inaugural...


The capital will be used to launch a serial of endometriosis tests and therapeutic programmes


Currently, the only available techniques for evaluating endometrial receptivity are laboratory methods requiring endometrial tissue biopsies


Supporting mental health innovation across the healthcare system will be central to securing transformation and improving patient outcomes


Women expressed unease when talking about menopause at work, due to male dominated environments


Hera Biotech is developing the world’s first molecular, cell-based test for diagnosing and staging endometriosis

The research could help clinicians better predict patient response to existing medicines


Compared to other existing long-acting forms, contraceptive microneedle array patches can be self-administered